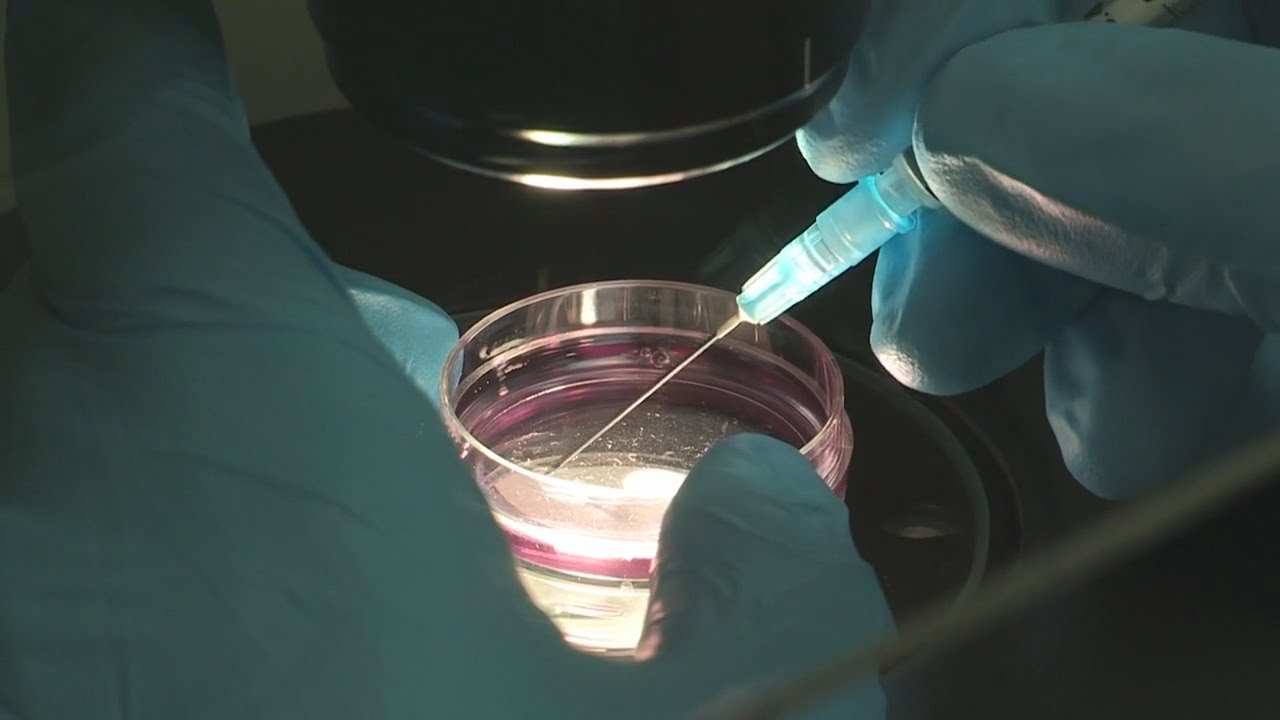
MOOC côté labo : La reprogrammation cellulaire au laboratoire

Le pouvoir des cellules souches
Автор: Inserm
Загружено: 2021-02-23
Просмотров: 18010
Описание:
Un enfant visite un laboratoire où l’on cultive des cellules souches. Munie d’un casque de réalité virtuelle permettant de dialoguer avec ces-dernières, une chercheuse lui décrit ce qu'elles sont et leurs propriétés, montrent comment elles se transforment et se spécialisent, et expliquent pourquoi et comment elles peuvent être utilisées en thérapie cellulaire.
Le film a été produit par le service information scientifique et communication de la délégation régionale Inserm Provence-Alpes-Côte d’Azur et Corse. Le contenu a été réalisé grâce aux contributions d’Annie Ladoux (chercheuse Inserm à l’iBV), Michel Bidet (correspondant communication Inserm à l’iBV), Camilia Jallab (attaché de recherche clinique au CHU de Nice) et Simon Lachambre (ingénieur de la plateforme PRISM à l’iBV), à l’implication de l’équipe de Christian Dani « Cellules souches et différenciation », et aux relectures de Bernard Binetruy, directeur de recherche Inserm et Nicolas Emmanuelli, Responsable du service information scientifique et communication Inserm Provence-Alpes-Côte d'Azur et Corse.
Scénario : Annie Ladoux
Réalisation : Margo Production
Musique : AudiGreen
Images : Inserm/CNRS/Université Côte d'Azur
Collaboration : Institut de biologie Valrose (iBV - Université Côte d'Azur/CNRS/Inserm)
Повторяем попытку...

Доступные форматы для скачивания:
Скачать видео
-
Информация по загрузке:








![Пожалуй, главное заблуждение об электричестве [Veritasium]](https://imager.clipsaver.ru/6Hv2GLtnf2c/max.jpg)